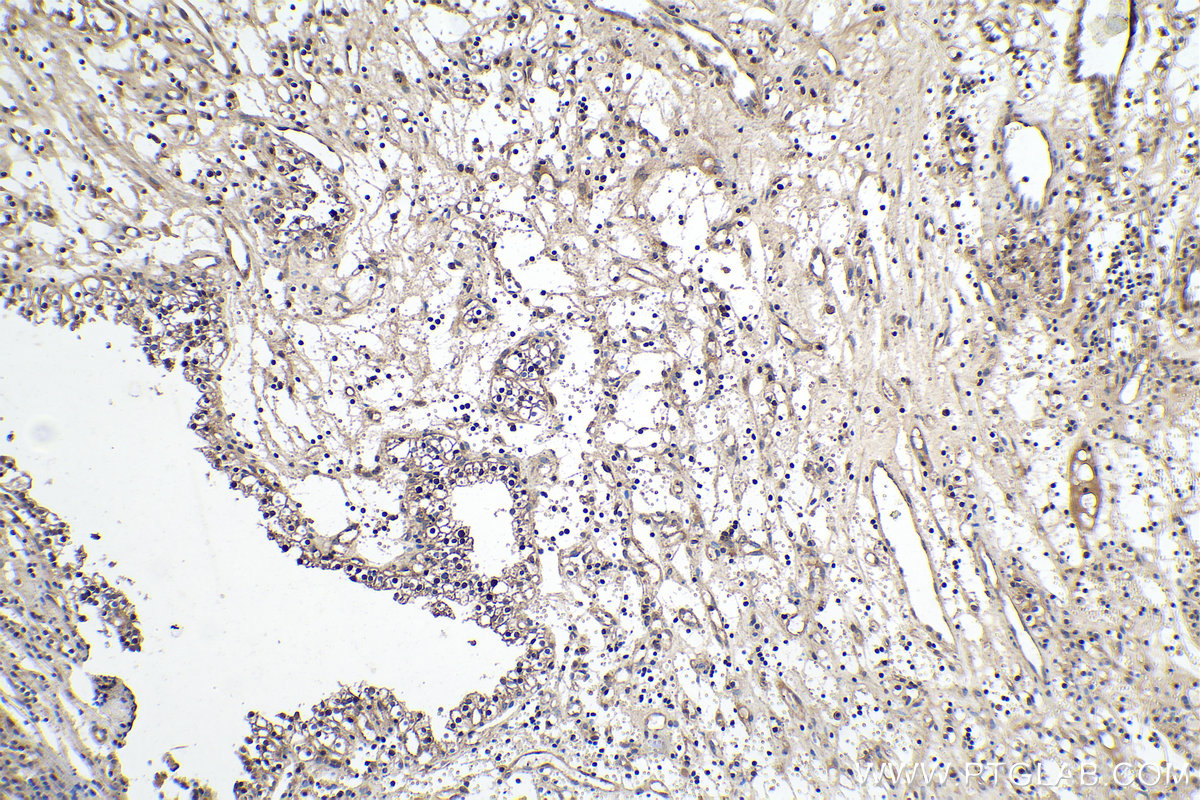

验证数据展示
经过测试的应用
| Positive WB detected in | Caco-2 cells, MCF-7 cells, NIH/3T3 cells, U2OS cells, HEK-293 cells |
| Positive IHC detected in | human renal cell carcinoma tissue, human gliomas tissue Note: suggested antigen retrieval with TE buffer pH 9.0; (*) Alternatively, antigen retrieval may be performed with citrate buffer pH 6.0 |
| Positive IF/ICC detected in | U2OS cells |
推荐稀释比
| 应用 | 推荐稀释比 |
|---|---|
| Western Blot (WB) | WB : 1:500-1:2000 |
| Immunohistochemistry (IHC) | IHC : 1:250-1:1000 |
| Immunofluorescence (IF)/ICC | IF/ICC : 1:50-1:500 |
| It is recommended that this reagent should be titrated in each testing system to obtain optimal results. | |
| Sample-dependent, Check data in validation data gallery. | |
产品信息
10934-1-AP targets Cyclin D2 in WB, IHC, IP, ELISA applications and shows reactivity with human, mouse samples.
| 经测试应用 | WB, IHC, ELISA Application Description |
| 文献引用应用 | WB, IHC, IP |
| 经测试反应性 | human, mouse |
| 文献引用反应性 | human, mouse, rat, pig, bovine, sheep, goat |
| 免疫原 |
CatNo: Ag1377 Product name: Recombinant human CCND2 protein Source: e coli.-derived, PGEX-4T Tag: GST Domain: 1-289 aa of BC010958 Sequence: MELLCHEVDPVRRAVRDRNLLRDDRVLQNLLTIEERYLPQCSYFKCVQKDIQPYMRRMVATWMLEVCEEQKCEEEVFPLAMNYLDRFLAGVPTPKSHLQLLGAVCMFLASKLKETSPLTAEKLCIYTDNSIKPQELLEWELVVLGKLKWNLAAVTPHDFIEHILRKLPQQREKLSLIRKHAQTFIALCATDFKFAMYPPSMIATGSVGAAICGLQQDEEVSSLTCDALTELLAKITNTDVDCLKACQEQIEAVLLNSLQQYRQDQRDGSKSEDELDQASTPTDVRDIDL 种属同源性预测 |
| 宿主/亚型 | Rabbit / IgG |
| 抗体类别 | Polyclonal |
| 产品类型 | Antibody |
| 全称 | cyclin D2 |
| 别名 | CCND2, G1/S-specific cyclin-D2, G1/S specific cyclin D2, Cyclin D |
| 计算分子量 | 32 kDa |
| 观测分子量 | 34 kDa |
| GenBank蛋白编号 | BC010958 |
| 基因名称 | Cyclin D2 |
| Gene ID (NCBI) | 894 |
| RRID | AB_2275319 |
| 偶联类型 | Unconjugated |
| 形式 | Liquid |
| 纯化方式 | Antigen affinity purification |
| UNIPROT ID | P30279 |
| 储存缓冲液 | PBS with 0.02% sodium azide and 50% glycerol, pH 7.3. |
| 储存条件 | Store at -20°C. Stable for one year after shipment. Aliquoting is unnecessary for -20oC storage. |
背景介绍
CCND2 belongs to the highly conserved cyclin family, whose members are characterized by a dramatic periodicity in protein abundance through the cell cycle. Cyclins function as regulators of CDK kinases. CCND2 forms a complex with and functions as a regulatory subunit of CDK4 or CDK6, whose activity is required for cell cycle G1/S transition. CCND2 has been shown to interact with and be involved in the phosphorylation of tumor suppressor protein Rb. High level expression of CCND2 was observed in ovarian and testicular tumors.
实验方案
| Product Specific Protocols | |
|---|---|
| IF protocol for Cyclin D2 antibody 10934-1-AP | Download protocol |
| IHC protocol for Cyclin D2 antibody 10934-1-AP | Download protocol |
| WB protocol for Cyclin D2 antibody 10934-1-AP | Download protocol |
| Standard Protocols | |
|---|---|
| Click here to view our Standard Protocols |
发表文章
| Species | Application | Title |
|---|---|---|
Nature SOX2 controls tumour initiation and cancer stem-cell functions in squamous-cell carcinoma. | ||
Cancer Cell The Oncogenic Transcription Factor RUNX1/ETO Corrupts Cell Cycle Regulation to Drive Leukemic Transformation.
| ||
Mol Cancer LncRNA TROJAN promotes proliferation and resistance to CDK4/6 inhibitor via CDK2 transcriptional activation in ER+ breast cancer. | ||
Dev Cell Vangl2 limits chaperone-mediated autophagy to balance osteogenic differentiation in mesenchymal stem cells. | ||
Kidney Int Transcription factor MafB may play an important role in secondary hyperparathyroidism. | ||
Front Immunol Comprehensive single-cell and bulk transcriptomic analyses to develop an NK cell-derived gene signature for prognostic assessment and precision medicine in breast cancer |